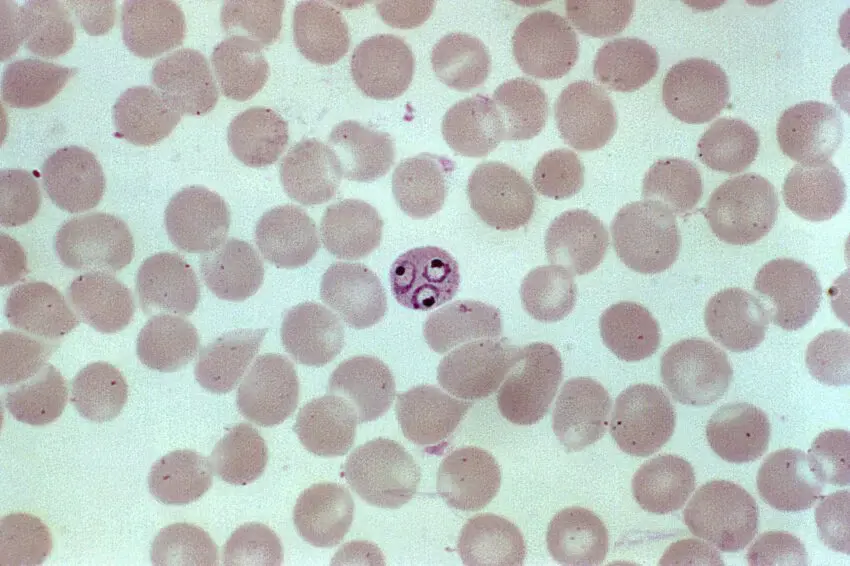

Главная причина онкологии
Главный регулятор, стоящий за развитием клеток, продуцирующих антитела, был идентифицирован в исследовании исследователей Weill Cornell Medicine. Полученные данные позволяют по-новому взглянуть на внутреннюю работу иммунной системы и могут помочь понять, как развиваются ткани и как возникают определенные виды рака.
Исследование, опубликованное 23 сентября в журнале Nature Immunology, объединило вычислительный анализ с передовой молекулярной биологией и геномными методами, чтобы идентифицировать белок Oct2 как ключевой детерминант гуморального иммунного ответа B-клеток.
Во время инфекции или после вакцинации зрелые В-клетки образуют зародышевые центры, своего рода всплывающее учебное заведение. Там клетки мутируют и реорганизуют свои гены, кодирующие антитела, до тех пор, пока либо не произведут улучшенное антитело, либо не умрут. Этот процесс играет центральную роль в реакции организма на многие патогены, но он также чреват опасностью; плохо расположенные мутации В-клеток могут вызвать лимфоидный рак.
«Все наши клетки обладают защитными механизмами против мутации, но В-клетки на самом деле делают наоборот; они специализируются на мутации, и делают это очень быстро».
Предыдущие исследования показали, что В-клетки контролируют созревание своих зародышевых центров, изменяя доступность различных частей их геномов и запуская каскады изменений экспрессии генов, чтобы направлять и ограничивать их развитие. Но что координирует все эти сигналы?
Чтобы ответить на этот вопрос впервые применили вычислительный подход, картируя все изменения регуляции генов, которым подвергаются созревающие В-клетки.